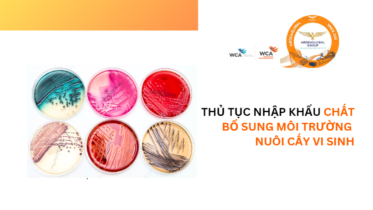
THỦ TỤC NHẬP KHẨU CHẤT BỔ SUNG MÔI TRƯỜNG NUÔI CẤY VI SINH

THỦ TỤC NHẬP KHẨU BÀN MỔ THỦY LỰC
BÀN MỔ THỦY LỰC phân loại gì?
Thủ tục nhập khẩu BÀN MỔ THỦY LỰC?
Thuế nhập khẩu của BÀN MỔ THỦY LỰC là bao nhiêu?
Thuế VAT của BÀN MỔ THỦY LỰC là bao nhiêu
Mã HS Code của BÀN MỔ THỦY LỰC là bao nhiêu?
Làm thế nào để vận chuyển hàng từ nước ngoài về tận kho ở Việt Nam?